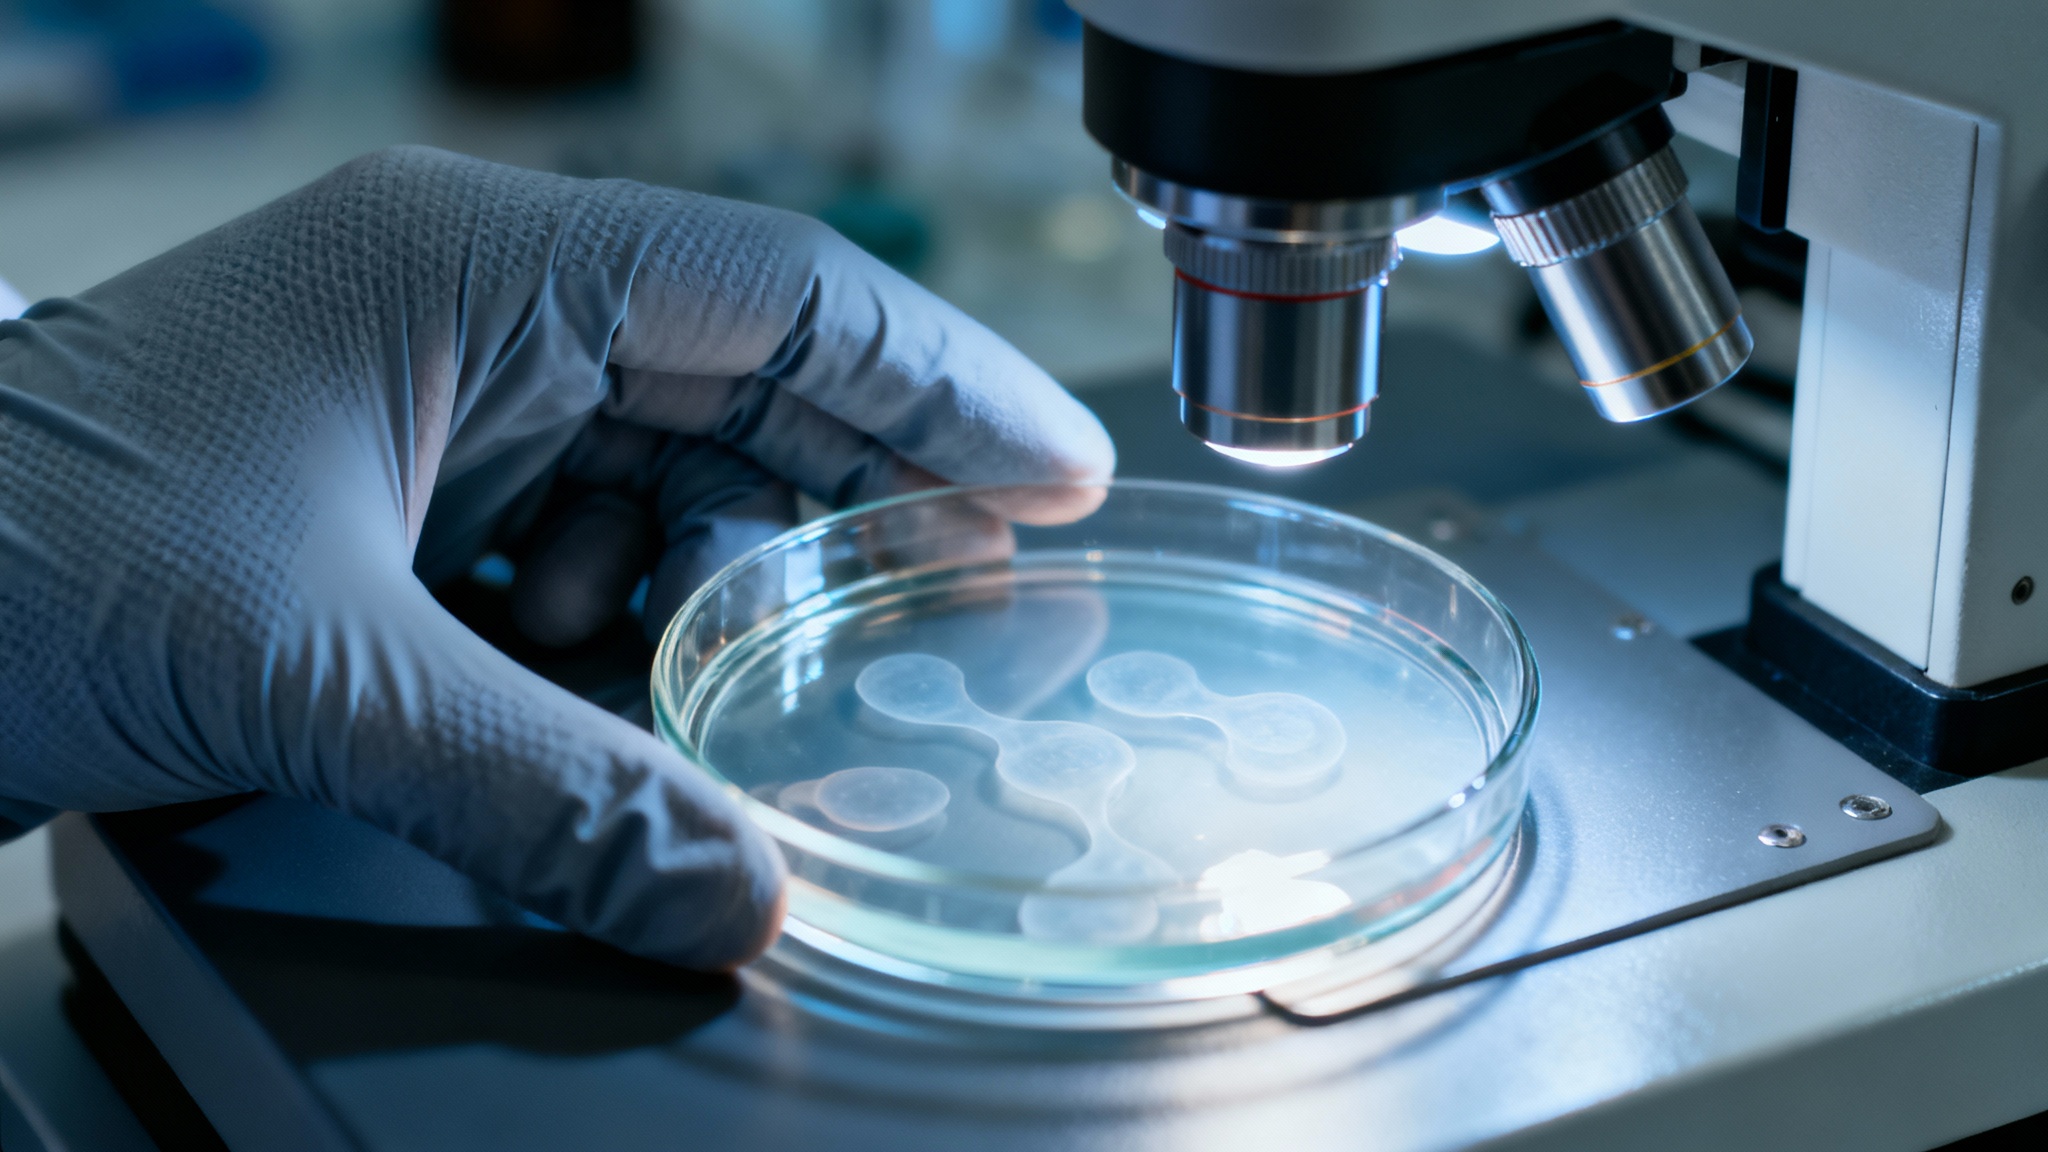
Des premiers essais très encourageants

Une lueur d’espoir pour le cœur : un gène fœtal pourrait permettre aux cellules cardiaques de se régénérer
Auteur: Mathieu Gagnon
On nous a toujours dit que le cœur était fragile. Une fois qu’il est abîmé, par une crise cardiaque par exemple, les dégâts sont là pour de bon. C’est une idée un peu décourageante, n’est-ce pas ? On traite les symptômes, on essaie de vivre avec, mais la réparation complète semblait impossible. C’est parce que nos cellules cardiaques d’adultes ont perdu la capacité de se régénérer. C’est comme ça, point.
Mais attendez. Des chercheurs de New York viennent peut-être de trouver un moyen de remonter le temps. Une étude récente, publiée dans npj Regenerative Medicine, suggère qu’il serait possible de réveiller une capacité de guérison endormie au plus profond de nos cellules. Une véritable lueur d’espoir pour des millions de personnes.
CCNA2, le gène oublié de notre jeunesse

Le secret se cacherait dans un gène au nom un peu barbare : Cyclin A2, ou CCNA2. Il faut voir ce gène comme un chef d’orchestre. Quand nous étions encore dans le ventre de notre mère, il était très actif, donnant le rythme pour que nos cellules cardiaques se multiplient et que notre petit cœur se construise. Mais peu après la naissance, l’interrupteur se met sur ‘off’. Et c’est fini. Presque.
Les scientifiques disent qu’il reste une toute petite capacité de réparation, mais elle diminue avec l’âge et elle est bien trop faible pour réparer les gros dégâts. L’idée, un peu folle mais géniale, est donc la suivante : et si on parvenait à rallumer cet interrupteur ?
Des premiers essais très encourageants
Ce n’est pas une simple supposition. L’équipe de recherche n’en est pas à son premier coup d’essai. En 2014 déjà, l’une des chercheuses principales, Hina Chaudry, avait participé à une expérience sur un cochon qui venait de subir une crise cardiaque. En activant le gène CCNA2 chez l’animal, ils ont observé que ses cellules cardiaques se remettaient à se diviser. Mieux encore, la fonction de son cœur s’est améliorée. Des résultats similaires ont ensuite été obtenus sur des souris.
C’est une démarche progressive, pleine de patience. Chaque étape a confirmé que cette piste était la bonne. C’était la preuve qu’il fallait continuer à creuser dans cette direction.
L'étape cruciale : les cellules humaines

Après les animaux, il fallait passer au test sur l’homme. Ou plutôt, sur des cellules humaines en laboratoire. Les chercheurs ont récupéré des cellules cardiaques de deux adultes, âgés de 41 et 55 ans. Pour y introduire le fameux gène CCNA2, ils ont utilisé une astuce de biologiste : un virus inoffensif, modifié pour servir de « transporteur ».
Imaginez un minuscule livreur qui dépose un colis (le gène) directement à l’intérieur de la cellule. Une fois le gène livré, ils ont utilisé des techniques d’imagerie pour observer, en direct, ce qui allait se passer. C’était un peu le moment de vérité.
Des résultats qui dépassent les espérances

Et les résultats ont été spectaculaires. Les cellules cardiaques, qui n’étaient plus censées pouvoir le faire, se sont mises à se diviser ! Le gène CCNA2 a réactivé en elles des programmes de développement, un peu comme s’il leur rappelait leur jeunesse. C’est déjà incroyable, mais le plus important est ailleurs.
Les nouvelles cellules créées, les « cellules filles », ont conservé toute leur structure et leur fonction de cellules cardiaques. Elles continuaient de se comporter normalement, notamment en gérant le calcium, un processus essentiel aux battements du cœur. Ce n’était donc pas une division anarchique, mais une véritable régénération contrôlée.
Conclusion : quel avenir pour nos cœurs ?

Soyons clairs, ce traitement ne sera pas disponible demain chez votre médecin. Il reste encore beaucoup de recherches à mener, notamment pour trouver le meilleur moyen d’administrer ce gène directement dans le cœur d’un patient et de mener des essais cliniques sur l’homme. Mais la porte est ouverte.
Cette découverte représente un espoir immense. On ne parle plus seulement de gérer les symptômes, mais bien de réparer le cœur. Un jour, peut-être, une thérapie génique de ce type pourrait aider un cœur à se reconstruire après une crise cardiaque, offrant une alternative à la transplantation ou à d’autres traitements lourds. Comme le disent les auteurs, c’est une stratégie « plus sûre et plus efficace » pour la régénération cardiaque. C’est une page de la médecine qui est peut-être en train de se tourner sous nos yeux.
Selon la source : medicalxpress.com










